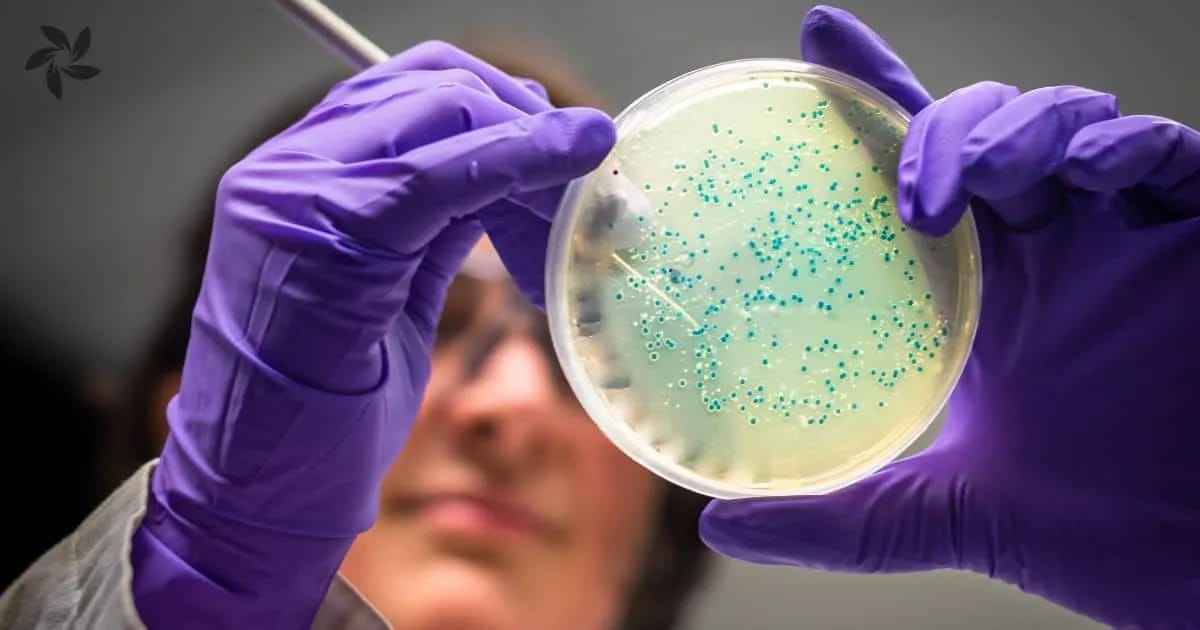
Parkinson en microbioom (2)

Wat we weten van parkinson en microbioom
Er zijn steeds meer aanwijzingen dat het darmmicrobioom een rol speelt in het ontstaan van parkinson, en ook een rol kan spelen in de behandeling. Hoe ‘werkt’ dat? Wat weten we tot nu toe van de relatie van parkinson en microbioom en welke concrete maatregelen kunnen parkinsonpatiënten nemen?

In dit artikel gaan we in op de relatie van parkinson en microbioom. Dat doen we aan de hand van een presentatie van een vooraanstaande onderzoeker op dit gebied, waar we in de vorm van een interview nader op ingaan.
Onze bijdrage heeft dus twee onderdelen.
Het eerste deel is een samenvatting van een presentatie van de Duitse onderzoeker dr. Filip Scheperjans bij No Silver Bullet. Scheperjans is gespecialiseerd in de behandeling van de ziekte van Parkinson. Hij was de eerste onderzoeker die de veranderingen in de darmmicrobiota bij degeneratieve ziekten van het zenuwstelsel beschreef. Scheperjans werkt als associate professor neurology in het Helsinki University Hospital. Zijn volledige presentatie met vraag- en antwoordsessie vind je hier.
Het tweede deel heeft een vraag- en antwoordvorm waarin we stilstaan bij de inzichten van Scheperjans en of we daar als parkinsonpatiënten iets mee kunnen. Als de darmmicrobiota van parkinsonpatienten afwijken heeft het dan zin om te proberen daar wijzingen in aan te brengen? Met andere woorden kunnen we als patiënten met de inzichten ons voordeel doen en bepaalde onderdelen toepassen?
Eerste deel: samenvatting van The importance of the gut-brain axis in Parkinson’s
Presentatie door dr. Filip Scheperjans, associate professor of neurology , Helsinki University Hospital.
Het belang van de gut-brain axis, de darm-brein-as, bij parkinson is een onderwerp waar we al ongeveer tien jaar over spreken, maar nog steeds maar een topje van de ijsberg van weten. In zijn presentatie laat Scheperjans een figuur zien met de evolutie van de symptomen van parkinson.

Scheperjans focust niet alleen op de bekende motorsymptomen na de diagnose, maar laat zien dat er vóór de diagnose al symptomen zijn zoals slaapstoornissen, depressie en angststoornissen, en dat er ver daarvoor, soms al twintig jaar, signalen van constipatie kunnen zijn.
Als we de oorzaak van parkinson willen onderzoeken zijn de darmproblemen een belangrijk aanknopingspunt, mogelijk ook voor een potentiële behandeling. Verschillende studies laten zien dat er een verhoogd risico op parkinson wordt gevonden bij mensen met darmproblemen zoals constipatie, maar ook prikkelbare darm-syndroom en chronische darmontsteking. Ook de aanwezigheid van de darmbacterie Helicobacter pylori en beschadiging van de darmwand zijn geassocieerd met het risico op parkinson.
Twee typen parkinson
Scheperjans bespreekt een concept dat uitgaat van twee typen parkinson: ‘brain–first’ en ‘body –first’ (of eigenlijk ‘darm-first’), waarbij respectievelijk de eerste symptomen in hersenen en darmen worden gevonden. Beide typen hebben verschillende mogelijke oorzaken en volgorde van symptomen, en hebben daardoor waarschijnlijk ook baat bij verschillende behandelingen.
Omdat Scheperjans geïnteresseerd is in bacteriën laat hij zien wat de rol is van antibiotica bij het risico op parkinson. Bij bepaalde typen antibiotica waarbij met name darmbacteriën worden bestreden was een gering effect te zien op het risico op parkinson, met name als de antibiotica 10–15 jaar tevoren werden gegeven. Geconcludeerd wordt dat het gebruik van antibiotica vooraf zou kunnen gaan aan de ontwikkeling van parkinson.
We weten al langer dat het brein invloed heeft op de darm, onder meer via het hormoon cortisol. Van meer recente datum is de kennis dat de bacteriën in de darm ook de hersenen kunnen beïnvloeden via de darmstofwisseling. De kennis hiervan is echter nog erg beperkt.
Wat wel bekend is, is dat de darm het grootste immuunorgaan van ons lichaam is. Bepaalde bacteriën in de darm produceren korteketen-vetzuren, meestal aangeduid met SCFA (short chain fatty acids). Deze vetzuren worden geproduceerd door het fermenteren van plantenvezels en hebben een positief effect op het immuunsysteem in de darm, en ook op de algemene gezondheid. In patiënten met parkinson zijn SCFA-producerende bacteriën (zoals Prevotella) minder aanwezig.
Andere bacteriën zoals Akkermansia, Bifidobacteria en Lactobacillus zijn juist verhoogd. Deze laatste worden ook als probiotica gebruikt. Probiotica zijn levende bacteriën die een gunstig effect kunnen hebben op de gezondheid. Maar de probiotica verklaren niet de toename van de bacteriën bij deze patiënten met parkinson. Ook zijn deze bacteriën geassocieerd met symptomen en de progressie van parkinson.
Uit onderzoek blijkt dat parkinsonpatiënten bepaalde bacteriën te weinig hebben en andere juist te veel. Zie onderstaand overzicht.

Het is belangrijk om te begrijpen hoe dit zou werken in verband met mogelijke nieuwe behandelopties. Een voorbeeld hiervan is Prevotella die bij parkinsonpatienten met een progressievere vorm van de ziekte minder aanwezig zijn dan bij patiënten met een meer stabiele ziekte. De laatste groep had ook minder darmproblemen.
Lagere butyraat-niveaus, een SCFA, blijken geassocieerd te zijn met hogere depressiescores, net als minder SCFA-producerende bacteriën.
Mogelijke mechanismes
De conclusie is dat klinische symptomen en de rol van darmmicrobiota mogelijk aanleiding geven tot het ontwikkelen van hierop gebaseerde therapeutische interventies. Wat zijn daarbij de mogelijke mechanismes?
Door een verandering van het microbioom bij parkinson naar een meer pro–inflammatoire (=ontstekingsbevorderende) samenstelling, samen met barrière-disfunctie, kunnen potentieel ziekmakende componenten zoals LPS (lipopolysacharide afkomstig van de celwand van bacteriën) in contact komen met de cellen van de darmwand. Dat kan een laaggradige ontsteking opleveren waarbij het eiwit alfa–synuclein (dat nodig is voor de communicatie van hersencellen) kan klonteren, wat uiteindelijk resulteert in een bloed–brein-disfunctie en ontsteking in het centrale zenuwstelsel.
Bepaalde bacteriën kunnen ook effect hebben op sommige soorten medicatie, zoals levodopa waardoor dat in de darm gemetaboliseerd wordt en niet meer beschikbaar is voor de hersenen. Het bacteriële tyrosine decarboxylase-enzym dat hiervoor verantwoordelijk is wordt niet geremd door componenten aanwezig in de levodopatabletten.
Het microbioom bij de behandeling van parkinson
Hoe kunnen we het microbioom inzetten bij de behandeling van parkinson? Allereerst zouden probiotica kunnen worden gebruikt. Systematische reviews en meta-analyses laten zien dat er een positief effect is op constipatie en op kwaliteit van leven, maar geen effect op de motorsymptomen.
Er zijn ook studies gedaan met prebiotica waarmee de darmbacteriën gevoerd worden, zoals plantenvezels en resistent zetmeel, maar daarvan zijn nog geen systematische reviews beschikbaar.
Fecale microbiota transplantatie (FMT ofwel poeptransplantatie) is een extreem werkzame therapie voor het bestrijden van infecties met de Clostridium difficile-bacterie. Hierbij wordt een gezond microbioom getransplanteerd in een patiënt met een verstoorde bacteriesamenstelling in de darm. De behandeling wordt geacht veilig te zijn en is ook toegepast bij parkinsonpatienten. Scheperjans laat een wetenschappelijk onderzoek uit Gent zien waarbij er na 12 maanden een gering maar klinisch relevant effect wordt gezien van de FMT-donor ten opzichte van een auto-FMT.
Scheperjans’ eigen onderzoeksgroep heeft in 2024 een studie gepubliceerd waarbij de controlegroep alleen fysiologisch zout kreeg. In deze studie werden uitsluitend parkinsonpatiënten opgenomen met een abnormale microbiota-compositie, omdat ervan uit werd gegaan dat dit de populatie is die het meeste voordeel van de behandeling zou hebben.
In de behandelde groep zagen de onderzoekers meer gastro-intestinale symptomen maar geen effect op motorsymptomen, terwijl er wel een verandering was van de microbiële samenstelling op de korte termijn. Na 12 maanden was het effect niet meer aanwezig, terwijl tot verwondering van de onderzoekers bij de placebogroep na 12 maanden een stijging te zien was naar een niet afwijkende microbiota-samenstelling bij de patiënten. Ze zagen ook dat de placebogroep na 6 maanden een iets beter loopvermogen had en een verbetering van de gastrointestinale symptomen.
Uit de data wordt de conclusie getrokken dat alleen al het schoonmaken van de darm, dat werd gedaan voorafgaand aan de FMT maar ook in de placebogroep, al gelegenheid geeft tot de repopulatie van een minder afwijkende microbiota in ongeveer een derde van de patiënten. Het reinigen van de darm is nu onderwerp van een vervolgstudie.
Problemen in het maagdarmkanaal
In het laatste deel van zijn lezing gaat Scheperjans in op het feit dat bij parkinson allerlei problemen in het maagdarmkanaal worden geconstateerd, zoals bepaalde bijwerkingen van medicatie, slijmverlies uit de mond, slikproblemen etc. Hierbij zijn bepaalde lokale behandelingen mogelijk zoals kauwgom kauwen en sommige medicatie. Scheperjans besteedt aandacht aan het feit dat tabletten overal in het maagdarmkanaal kunnen blijven vastzitten, waardoor een fluctuatie van levodopa-niveaus kan ontstaan. Andere manieren van toedienen kunnen dan overwogen worden.
Scheperjans adviseert om te screenen op de aanwezigheid van Helicobacter pylori omdat dat geassocieerd is met kanker, en om maatregelen te nemen als ze gedetecteerd wordt.
Twee typen constipatie
Scheperjans signaleert dat er twee typen constipatie zijn. In de eerste plaats is er langzame transit-constipatie waarbij de darm heel langzaam beweegt als gevolg van disfunctie van het autonome zenuwstelsel. In de dikke darm wordt water verwijderd uit de ontlasting waardoor ze als ze lang in de darm blijft zitten steeds harder wordt. Een tweede vorm van constipatie komt voor als de spier bij de anus niet voldoende ontspant, zodat de ontlasting blijft zitten.
De behandeling van de twee vormen zijn verschillend. De eerste vorm wordt behandeld met meer water drinken, voedingsvezels eten en bewegen. Ook macrogol die de ontlasting zachter maakt kan worden gebruikt. Bij de tweede constipatievorm is een andere behandeling nodig met bijvoorbeeld een a>klysma. /a>Ook een andere zitpositie met de benen omhoog kan zorgen voor een betere doorgang.
Diëten
Tot slot geeft Scheperjans als dieetadvies het mediterraan dieet en het MIND-dieet dat veel vezels en weinig vlees (maar wel vis) omvat. Het dieet is rijk aan antioxidanten en goede voedingsstoffen. Met het dieet kan het risico op parkinson worden verminderd zelfs als er pas laat, na de 65-jarige leeftijd, mee wordt begonnen. Verschillende artikelen hebben positieve effecten laten zien.
Tweede deel: wat kunnen parkinsonpatiënten met de inzichten van Scheperjans?
De suggestie dat het microbioom een rol kan spelen bij het ontstaan en de behandeling van parkinson is veelbelovend en verdient nader onderzoek. Wat kunnen huidige patiënten met het inzicht? In een interview van Peter Gunst met Anje te Velde wordt nader op de inzichten ingegaan.
Peter Gunst: Ik vind het heel opmerkelijk dat wij, parkinsonpatiënten, afwijkende microbiota hebben. Ik vraag me dan meteen af: kunnen we iets met die wetenschap? Eerder had ik al gelezen over het verstoorde microbioom bij parkinson. Om die reden heb ik enkele jaren geleden mijn neuroloog gevraagd om mij door te verwijzen naar een maag-darm-leverarts. Maar dat deed ze niet, maag-darm-leverartsen hebben geen kennis van parkinson, zei de neuroloog. Jij werkt zelf in een ziekenhuis, Anje. Zou je als parkinsonpatiënt baat hebben bij een bezoek aan een maag-darm-leverarts en kan die ook het microbioom in kaart brengen?
Anje te Velde: Ik denk dat er weinig maag-darm-leverartsen zijn die vanuit een behandeloptie het microbioom zullen gaan analyseren. We weten hier nog te weinig van om de uitslag van een microbioomanalyse te kunnen vertalen naar een directe interventie. Wat wel kan als parkinsonpatiënt is zorgen dat de bacteriën in de darm zo optimaal mogelijk kunnen functioneren. Dat houdt dus onder meer in zorgen voor het eten van voldoende vezels uit onbewerkte voeding en weinig suiker.
Peter: Ik lees vaak dat parkinson zich bij iedere patiënt anders manifesteert. Dat zal dan bij de samenstelling van het microbioom ook wel zo zijn. Waar Scheperjans het niet over heeft is de mogelijkheid om eerst onderzoek te doen naar de samenstelling van het microbioom, zodat je heel gericht kunt nagaan welke bacteriën verminderd en welke vermeerderd moeten worden. Heeft het zin om dat eerst in kaart te brengen?
Anje: Het klopt dat het microbioom bij iedereen anders is. Je kunt het in kaart brengen om in grove lijnen een indruk te krijgen, zoals Scheperjans ook doet. Maar de vraag is wat je dan kunt doen met de wetenschap dat je van de ene bacteriesoort wat meer, en van de andere wat minder hebt. We weten niet wat dat betekent, omdat we niet weten wat een normale samenstelling is. We weten niet waar je de waarden die je vindt tegen kunt afzetten. Het lijkt raadzaam te beginnen met het eten van meer vezels, als je dat nog niet deed. Dat kan een dure test schelen.
Peter: Als je je microbioom toch in kaart wilt laten brengen, waar kun je dat dan doen? De maag-darm-leverarts lijkt hiervoor niet de aangewezen persoon. Zou dat kunnen bij een microbioomcentrum zoals Microbiome Center, Sanitas Humanus, MGlab of Inner Buddies?
Anje: Als je interesse hebt om het microbioom in kaart te brengen en je hebt het geld ervoor over kun je dat natuurlijk doen. Maar zoals al aangegeven zegt een enkele analyse niet veel omdat je niet weet wat je er mee moet. In de meeste microbioomstudies wordt het microbioom van een patiëntenpopulatie vergeleken met een gezonde populatie of voor en na een bepaalde interventie. Wat je als patiënt wel zou kunnen doen, als je de kosten ervoor over hebt, is een analyse voor en enige tijd na een leefstijlaanpassing te laten doen, en die te vergelijken om te zien of er iets ten goede is veranderd.
Peter: Moet je dan je pre- en probiotica blijven gebruiken?
Anje: Van probiotica is nog steeds niet duidelijk of ze daadwerkelijk effect hebben en hoe lang je ze zou moeten gebruiken. Prebiotica hoef je niet apart te nemen als je gezond eet. Soms is het wel lastig om voldoende vezels binnen te krijgen. Je zou deze dan kunnen toevoegen aan je voeding, bijvoorbeeld in de vorm van extra zemelen of gebroken lijnzaad.
Peter: Wordt de stoelgang ook weer beter bij een verbeterd microbioom? Of moet je daar aanvullende supplementen voor blijven gebruiken?
Anje: Het is te verwachten dat je als je gezond gaat eten ook een betere stoelgang krijgt. Daarover heb je echter geen zekerheid.
Peter: Laat zo’n onderzoek ook zien of je een lekkende darm hebt? Is daar doorgaans wat tegen te doen?
Anje: Je kunt apart een onderzoek laten doen naar een lekkende darm. Wederom is de vraag wat je als patiënt met die kennis gaat doen.
Dit artikel is gemaakt door dr. Anje A. te Velde in samenwerwerking met Peter Gunst. – Anje werkt bij UMC Amsterdam, Tytgat Institute for Liver and Intestinal Research, en is lid van de medische-wetenschappelijke adviesraad van Je Leefstijl Als Medicijn. – Peter is parkinsonpatiënt en coördinator parkinson en leefstijl bij Je Leefstijl Als Medicijn.
De presentatie van Filip Scheperjans is te vinden op YouTube.
In deze video gaat Peter Gunst in op de vraag welke rol voeding kan spelen bij omgaan met parkinson.
SupportgroepParkinson en leefstijl
Supportgroep voor mensen met parkinson die leefstijl inzetten voor een beter leven.
Nieuwsbrief
Wekelijks tips en artikelen in je inbox.
Gerelateerde artikelen
ArtikelGezonde voeding voor hersenaandoeningen en mentale klachten: 2 diëten die werken
Gezonde voeding voor hersenaandoeningen? Lees hoe je mentale klachten en neurologische aandoeningen kunt aanpakken met je dieet.
WetenschapMetabole disfunctie: hoe leefstijl het verschil kan maken
Metabole disfunctie is de oorzaak van de meest voorkomende chronische ziektes. Wat is het en wat kunnen we ertegen doen?